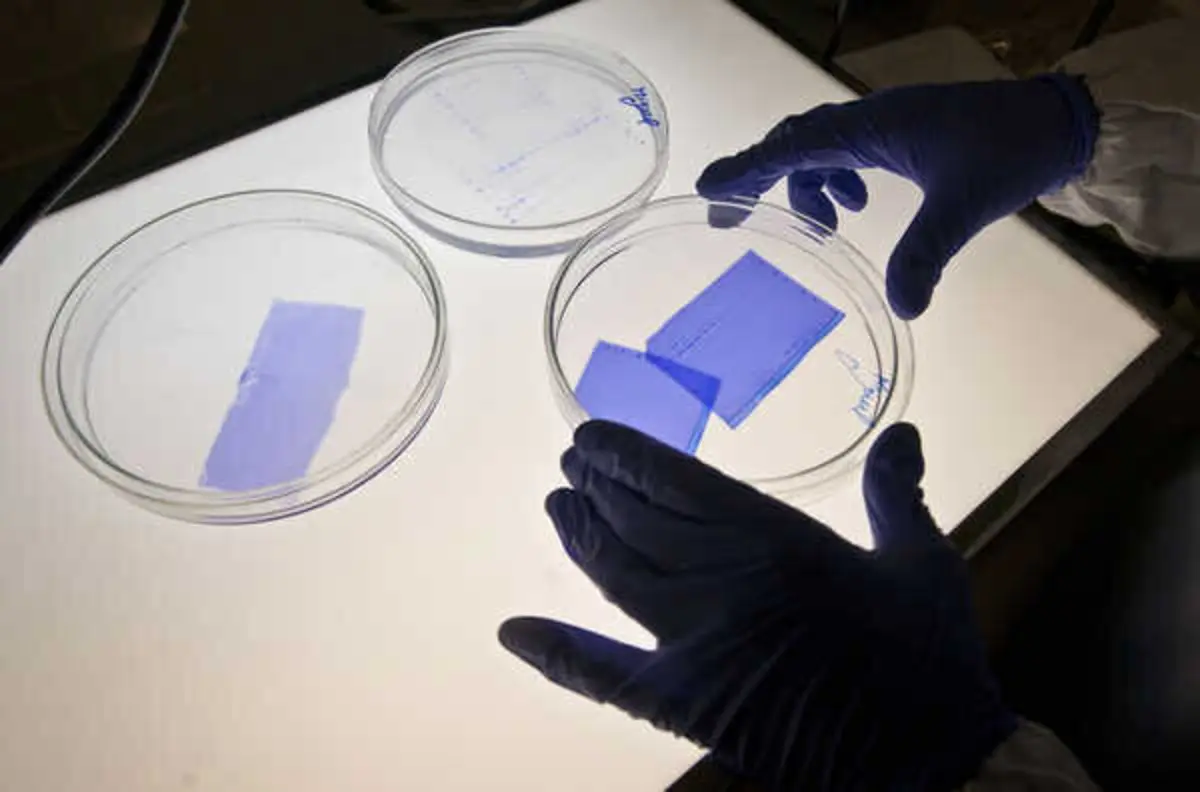
Imagem de contexto do artigo Ipatimup vence prémio mundial e recebe 50 mil dólares para investigação científica

Ipatimup vence prémio mundial e recebe 50 mil dólares para investigação científica
Leonel de Castro / Global Imagens
O Instituto de Patologia Molecular e Imunologia da Universidade do Porto (Ipatimup) venceu o prémio mundial "Precision Oncology Patient Innovation Awards" de 2023 e irá receber uma bolsa de 50 mil dólares (cerca de 47,6 mil euros).
Corpo do artigo
O prémio é patrocinado pelo laboratório alemão Bayer, que anunciou que o Ipatimup foi selecionado através de um painel de avaliação independente.
O Ipatimup tem como objetivo estudar as causas e evolução das doenças oncológicas e, desta forma, contribuir na eficiência do tratamento nos cuidados oncológicos da população portuguesa e mundial.
Segundo a Bayer, a bolsa irá apoiar o projeto POPCARE, que visa "responder a necessidades não satisfeitas em oncologia de precisão através da criação de uma plataforma que facilite a utilização de terapias direcionadas e tratamentos inovadores em oncologia pediátrica".
"Esta bolsa POPIA vai apoiar o lançamento do POPCARE, uma iniciativa que aproveita o poder da medicina de precisão, da definição de perfis genómicos e da colaboração entre setores para assegurar que as terapias direcionadas e os tratamentos inovadores contra o cancro chegam às crianças que mais precisam deles", afirma Jorge Lima, vice-diretor do Ipatimup.
Segundo a nota hoje divulgada, a oncologia de precisão é um campo em crescimento no qual os cancros são testados e tratados de acordo com a sua impressão digital única de ADN, ajudando a personalizar os cuidados oncológicos.
